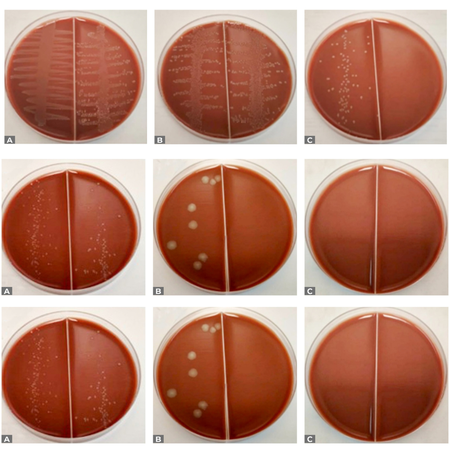
Eficácia antimicrobiana comparativa da N-acetilcisteína e do hidróxido de cálcio contra Enterococcus faecalis: estudo in vitro

A Inteligência Artificial está superando a inteligência humana ou estamos apenas nos esquecendo de como pensar?
Editorial
A Inteligência Artificial (IA) tem protagonizado avanços impressionantes e tem ganhado notoriedade nos últimos anos. Da geração de textos e imagens à realização de diagnósticos médicos, há uma sensação crescente e inquietante de que estamos sendo superados por máquinas. Mas será que a IA é realmente mais inteligente do que nós? Ou estamos apenas formando mal os profissionais?
Autores: Marco Antonio Húngaro Duarte, Murilo Priori Alcalde,

A Inteligência Artificial (IA) tem protagonizado avanços impressionantes e tem ganhado notoriedade nos últimos anos. Da geração de textos e imagens à realização de diagnósticos médicos, há uma sensação crescente e inquietante de que estamos sendo superados por máquinas. Mas será que a IA é realmente mais inteligente do que nós? Ou estamos apenas formando mal os profissionais?
Leia mais
OBJETIVO: Relatar o tratamento de uma lesão endo-periodontal em um molar superior com anatomia em “C” e apresentar o reparo completo, após um ano de acompanhamento, com tomografia computadorizada de feixe cônico (TCFC). RELATO DE CASO: Paciente do sexo masculino, 15 anos de idade, procurou atendimento relatando dor, dificuldade mastigatória e presença de fístula na mucosa vestibular do dente #17. A fistulografia mostrou o trajeto do cone de guta-percha até a região da furca,...
Leia mais
OBJETIVO: O objetivo foi avaliar, por meio de microtomografia computadorizada (micro-CT), a capacidade de modelagem e segurança de diferentes instrumentos em canais mesiais de molares inferiores após o uso a 37ºC e 20ºC. MÉTODOS: Trinta e seis molares inferiores humanos extraídos foram escaneados por micro-CT e divididos em três grupos (n=12), conforme o sistema de instrumentação: Reciproc Blue (REC), ProDesign R (PDR) e X1 Blue File (X1), subdivididos por temperatura (n=6; 20ºC e...
Leia mais
INTRODUÇÃO: Uma reabsorção externa inflamatória apresenta diagnóstico desafiador na identificação da sua extensão e na natureza do processo, especialmente quando o defeito de reabsorção se encontra nas faces vestibular ou palatina. OBJETIVO: Descrever o diagnóstico e tratamento de um paciente com uma reabsorção externa inflamatória em dente permanente associado a um quadro de periodontite avançada. RELATO DE CASO: Paciente apresentando periodontite com extensa perda óssea...
Leia mais
INTRODUÇÃO: Fístulas cutâneas de origem dentária representam um desafio diagnóstico e terapêutico, especialmente quando há manifestações extrabucais. A tomografia computadorizada de feixe cônico (TCFC) pode ser fundamental para identificar canais previamente não tratados e guiar retratamentos minimamente invasivos. OBJETIVO: Esse artigo tem como objetivo apresentar o caso clínico de um paciente do sexo masculino, com de 19 anos de idade, que apresentou uma lesão extrabucal...
Leia mais
OBJETIVO: Avaliar e comparar a efetividade antimicrobiana e a velocidade de ação da N-acetilcisteína (NAC) e do hidróxido de cálcio [Ca(OH)₂] contra Enterococcus faecalis ao longo de 24, 48, 72 e 96 horas, por meio de análise microbiológica in vitro. MATERIAL E MÉTODOS: Culturas padronizadas de E. faecalis (ATCC 29212) foram expostas à NAC (200 mg/mL) e ao Ca(OH)₂ por diferentes períodos de incubação. O grupo controle consistiu em culturas bacterianas sem medicação. As...
Leia mais
INTRODUÇÃO: A análise reológica surgiu como uma abordagem promissora para o estudo das propriedades de cimentos endodônticos. OBJETIVO: O objetivo deste estudo foi avaliar, utilizando análise reológica, a viscosidade de dois cimentos endodônticos: à base de silicato de cálcio e à base de resina epóxi. MÉTODOS: Bio-C Sealer Plus Ion+ (Angelus, Brasil) e AH Plus Jet (Dentsply, Alemanha) foram medidos utilizando um reômetro rotacional de alto desempenho com controle de tensão,...
Leia mais
OBJETIVO: Avaliar a atividade antimicrobiana da água ozonizada e de uma solução de óleo essencial de melaleuca a 5%, em comparação com o hipoclorito de sódio (NaOCl) a 2,5%, utilizando contaminação intratubular com Candida albicans, Enterococcus faecalis e Staphylococcus aureus. MATERIAL E MÉTODOS: Sessenta e cinco pré-molares inferiores humanos recém-extraídos foram divididos em quatro grupos (n=20), de acordo com a solução de irrigação utilizada: NaOCl; solução de óleo...
Leia mais
INTRODUÇÃO: O sulco radicular é uma anomalia de desenvolvimento caracterizada por uma invaginação linear que se estende da coroa em direção à raiz, podendo estar localizada na face vestibular ou palatina. Sua presença pode predispor a alterações periodontais e endodônticas, dificultando o diagnóstico e comprometendo o prognóstico. OBJETIVO: Este relato descreve o tratamento endodôntico- -periodontal de um incisivo lateral superior direito com dois sulcos radiculares profundos,...
Leia mais
Artificial Intelligence (AI) has made impressive advances and gained notoriety in recent years. From generating text and images to making medical diagnoses, there's a growing and disturbing sense that we're being outmaneuvered by machines. But is AI really smarter than us? Or are we simply undertraining professionals? The question isn't trivial. Many see AI as a threat to critical thinking, creativity, and human autonomy. Tools that should help us often end up replacing us. Students turn to...
Leia mais
OBJECTIVE: To report the treatment of an endo-periodontal lesion in a maxillary molar with C-shaped anatomy and present complete healing after one year of follow-up with cone-beam computed tomography (CBCT). CASE REPORT: A 15-year-old male patient sought treatment complaining of pain, difficulty chewing, and the presence of a fistula on the buccal mucosa of tooth #17. Fistulography showed the gutta-percha cone extending to the furcation area, while periodontal probing revealed a pocket on...
Leia mais
OBJECTIVE: The aim of this study was to evaluate, using micro-computed tomography (micro-CT), the shaping ability and safety of different endodontic instruments in mesial canals of mandibular molars after use at 37ºC and 20ºC. METHODS: Thirty-six extracted human mandibular molars were scanned by micro-CT and divided into three groups (n=12) according to the instrumentation system: Reciproc Blue (REC), ProDesign R (PDR), and X1 Blue File (X1), and further subdivided by temperature (n=6; 20ºC...
Leia mais
INTRODUCTION: External inflammatory resorption presents a challenging diagnosis for identification of the extent and nature of the process, especially when the resorption defect is located on the buccal or palatal surfaces. OBJECTIVE: To describe the diagnosis and treatment of a patient with external inflammatory resorption in a permanent tooth associated with advanced periodontitis. CASE REPORT: The patient presented periodontitis with extensive bone loss in the lower anterior teeth and an...
Leia mais
INTRODUCTION: Cutaneous sinus tracts of dental origin represent a diagnostic and therapeutic challenge, particularly when extraoral manifestations are present. Cone-beam computed tomography (CBCT) can be pivotal in identifying previously untreated canals and guiding minimally invasive retreatment. METHODS: This article aims to present the clinical case of a 19-year-old male patient who presented with a persistent extraoral lesion in the right submandibular region, lasting two years.
Leia mais
OBJECTIVE: To evaluate and compare the antimicrobial effectiveness and speed of action of N-acetylcysteine (NAC) and calcium hydroxide [Ca(OH)₂] against Enterococcus faecalis over 24, 48, 72, and 96 hours using in vitro microbiological analysis. MATERIAL AND METHODS: Standardized cultures of E. faecalis (ATCC 29212) were exposed to NAC (200 mg/mL) and Ca(OH)₂ for different incubation periods. The control group consisted of bacterial cultures with no medicament. Colony-forming units...
Leia mais
INTRODUCTION: Rheological analysis has emerged as a promising approach for studying the properties of endodontic sealers. OBJECTIVE: The aim of this study was to evaluate the viscosity of two endodontic sealers: calcium silicate-based and epoxy resin-based, using rheological analysis. METHODS: Bio-C Sealer Plus Ion+ (Angelus, Brazil) and AH Plus Jet (Dentsply, Germany) were measured using a high-performance stress-controlled rotational rheometer, with the shear rate ranging from 0.0001 to...
Leia mais
OBJECTIVE: In this study, the antimicrobial activity of ozonated water and a 5% tea tree oil solution was evaluated in comparison to 2.5% sodium hypochlorite (NaOCl) using intratubular contamination with Candida albicans, Enterococcus faecalis and Staphylococcus aureus. Materials and methods: Sixty-five recently extracted human mandibular premolars were divided into four groups (n=20) according to the rinsing solution used: NaOCl; TTO - tea tree oil solution; OW - ozonated water (n=5)....
Leia mais
INTRODUCTION: The radicular groove is a developmental anomaly characterized by a linear invagination extending from the crown toward the root, which may be located on either the buccal or palatal surface. Its presence may predispose to periodontal and endodontic complications, hindering diagnosis and compromising prognosis. OBJECTIVE: This report describes the endodontic-periodontal management of a maxillary right lateral incisor with two deep radicular grooves, one on the buccal and the...
Leia maisCopyright © 1996 - 2024 DentalGO | Todos Direitos Reservados. DentalGO é uma marca Dental Press
Login